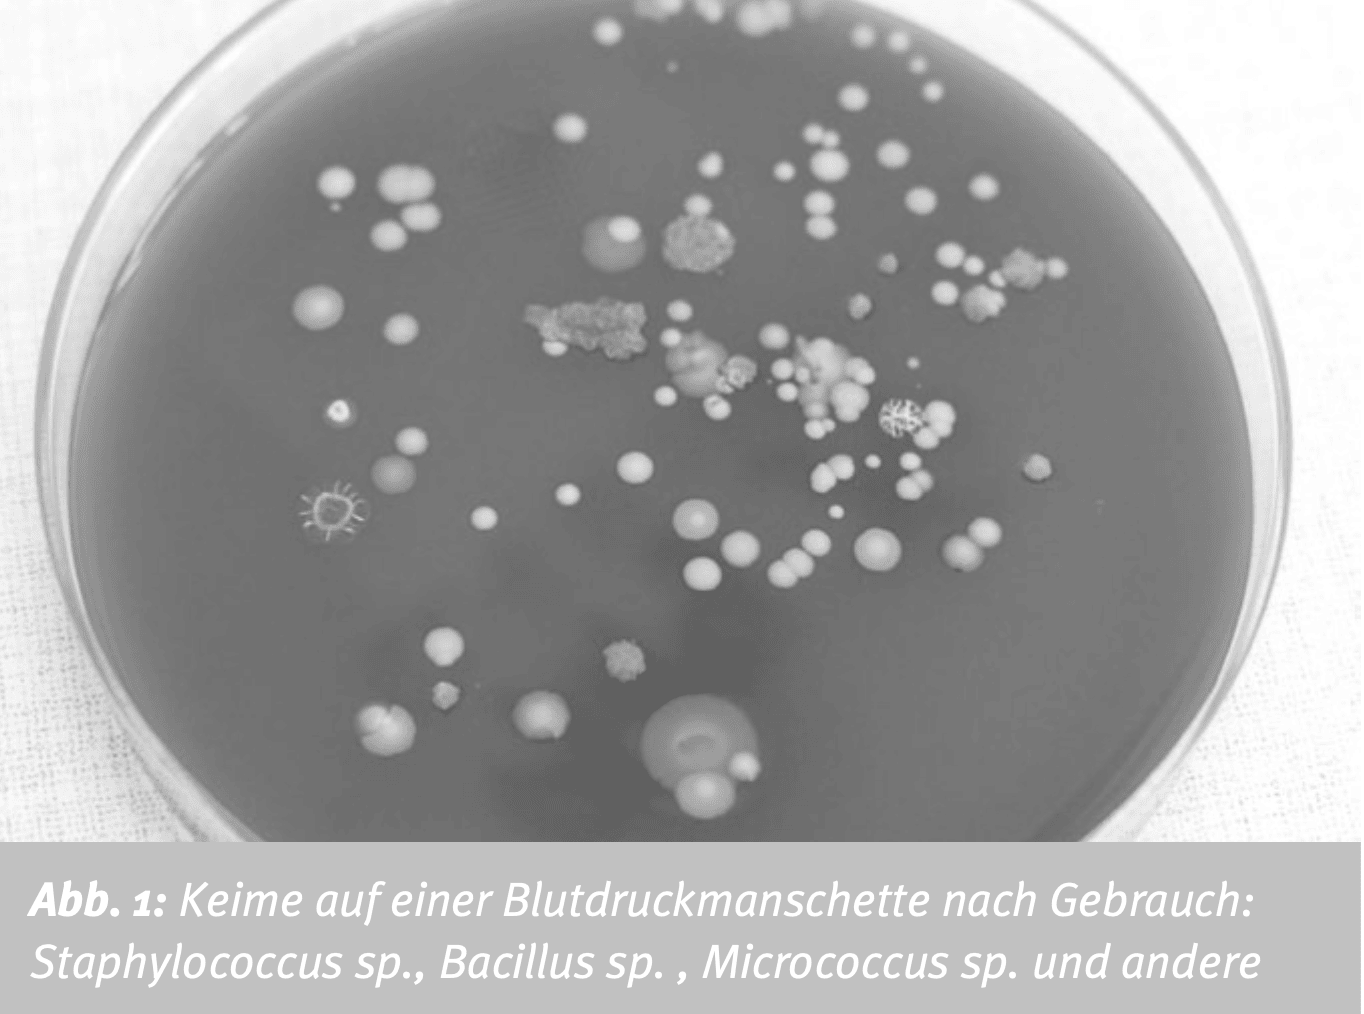

Das Problem bei Stoff und Klettverschluss
Venenstauer aus Stoff
Herkömmlicher Stoff-Venenstauer werden im klinischen Alltag nur sehr selten wirksam aufbereitet.
Allein in Deutschland werden täglich über eine Million Blutentnahmen durchgeführt. Dabei kommen sogenannte Stauschläuche bzw. Venenstauer zum Einsatz.
Die überwiegend textile Materialbeschaffenheit dieser Medizinprodukte ist für eine schnelle, zuverlässige und reproduzierbare Desinfektion im Routinebetrieb ungeeignet. Insbesondere das saugfähige Stoffgewebe sowie mechanische Komponenten wie Kunststoff- oder Klemmverschlüsse begünstigen die Anhaftung und Persistenz von Mikroorganismen und erschweren eine vollständige Keimreduktion.
Die unzureichende Aufbereitung führt dazu, dass Venenstauer als potenzielle Keimreservoire fungieren und zur Übertragung von Krankheitserregern zwischen Patientinnen und Patienten beitragen können. Bereits geringe Erregermengen können dabei ausreichen, um Infektionen auszulösen, insbesondere bei vulnerablen Personengruppen wie älteren Menschen, Kindern und immungeschwächten Patientinnen und Patienten. Zahlreiche mikrobiologische Untersuchungen belegen eine hohe Kontaminationsrate herkömmlicher Stoff-Venenstauer. Mittels Abklatschpräparaten konnten regelmäßig potenziell pathogene Keime nachgewiesen werden, darunter Staphylococcus aureus, der in einzelnen Studien auf bis zu 77,8 % der untersuchten Venenstauer identifiziert wurde.
Der routinemäßige Einsatz ohne konsequente, validierte Desinfektion begünstigt somit eine fortlaufende Keimverschleppung im klinischen Umfeld.

Die vollständige und schnellen Wischdesinfektion des selbstfindenden Magnetverschlusses sowie des durchgängigen Silikonbandes reduzieren das Risiko vom Keimübertragungen und senken zugleich Zeit-, Arbeits- und Kostenaufwand im klinischen Alltag.
Quellen
- Immunity & Ageing: a new journal looking at ageing from an immunological point of view.unity & Ageing: a new journal looking at ageing from an immunological point of view.
- Reduced bacterial contamination rates detected on silicone tourniquets compared to conventional tourniquets in clinical routine
- The effect of sterile versus non-sterile tourniquets on microbiological colonisation in lower limb surgery.
- Reducing the potential for phlebotomy tourniquets to act as a reservoir for meticillin-resistant Staphylococcus aureus.
- Poor hospital infection control practice in venepuncture and use of tourniquets.
- Potential risk of cross-infection during peripheral-venous access by contamination of tourniquets.
- Poor hospital infection control practice in hand hygiene, glove utilization, and usage of tourniquets.urniquets.
Blutdruck-Manschetten mit Klettverschluss
Auch Blutdruckmanschetten mit Klettverschluss können am Point-of-Care nicht wirksam desinfiziert werden.
Die nichtinvasive Blutdruckmessung gehört zu den am häufigsten durchgeführten Routineuntersuchungen im Krankenhaus. Blutdruckmanschetten kommen dabei täglich bei einer Vielzahl von Patientinnen und Patienten zum Einsatz, häufig mehrfach und patientenübergreifend. Herkömmliche Mehrweg-Blutdruckmanschetten bestehen überwiegend aus textilen Materialien und verfügen über Klettverschlüsse. Diese Materialkombination ist für eine rasche und zuverlässige Aufbereitung im klinischen Alltag ungeeignet, da Textilgewebe und Klettsysteme Krankheitserregern zahlreiche Haft- und Rückzugsorte bieten und eine effektive Desinfektion erschweren.
Der routinemäßige Einsatz ohne konsequente Desinfektion führt somit unweigerlich zur Keimverschleppung. Einmal-Blutdruckmanschetten können dieses Risiko reduzieren, sind jedoch aus Gründen der Nachhaltigkeit kritisch zu bewerten.
Reinigung der daisycuff-Blutdruckmanschette direkt am Point-of-Care
Die daisycuff Manschette hat keinen Klettverschluss und kann daher mit einer einfachen und schnellen Wischdesinfektion in Sekundenschnelle keimarm aufbereitet werden, wobei nachweislich 99,99% der koloniebildenden Einheiten (KBE) entfernt werden.
[Veröffentlichung der Studienergebnisse erfolgt in Kürze]
Quellen
- Abschlussbericht der Deutschen Nationalen Punkt-Prävalenzerhebung zu nosokomialen Infektionen und Antibiotika-Anwendung, 2022
- Blood Pressure Cuff as a Potential Vector of Pathogenic Microorganisms: A Prospective Study in a Teaching Hospital. Infection Control and Hospital Epidemiology, September 2006, Vol. 27, No. 9
- Klinikum Lippe, Newsletter „Hygiene aktuell“, Ausgabe 2, 2016


